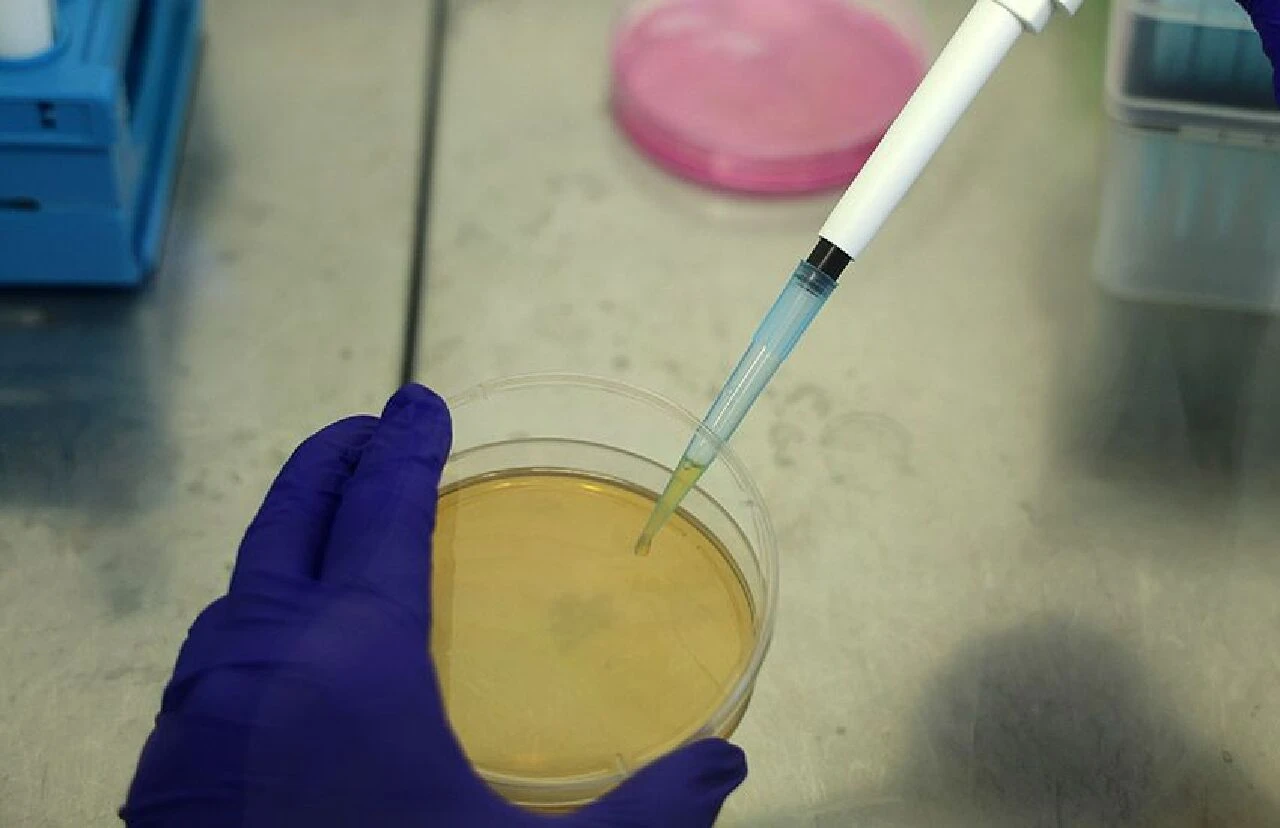
Maymun çiçeği vürüsüne çare Türkiye'de! Sivas'ın propolisi maymun çiçeğine şifa olacak - 1. Resim

Kategoriler
UYGULAMALAR
İstanbul
Koronavirüsten sonra dünyada maymun çiçeği virüsü alarmı verildi. Afrika’da etkisini gösteren maymun çiçeği ile ilgili bilimsel çalışmalara hız verildi. Yaz aylarının sona yaklaşmasıyla arı ürünlerinin sağımında sona yaklaşıldı. Arılar için büyük öneme sahip olan propolis alternatif tıpta tedavi yöntemlerinde büyük öneme sahip.
Gerçekleştirilen laboratuvar çalışmalarında propolisin kabarcıklı ağız iltihabı virüsüne karşı öldürücü etki gösterdiği ve çiçek hastalığı virüsünün etkisini 15 dakika içinde büyük oranda azalttığı gözlemlendi.
Sivas Cumhuriyet Üniversitesi İleri Teknoloji Uygulama ve Araştırma Merkezinde (CÜTAM) yürütülen çalışmalarda propolis farklı laboratuvar teknikleri ile tamamen suda çözünür hale getirilerek antimikrobiyal etkinliği yüksek oranda artırıldı. Bu bağlamda propolisin maymun çiçeğine karşı ne kadar etkili olduğunu görmek amacıyla çalışma başlatıldı.
Sivas'ta arıcılığın gelişmiş olmasından dolayı propolisin sıkça karşımıza çıktığını belirten Gıda Mühendisi Öğr.Gör. Esen Bilge Biçer, “Propolis arıların bitkilerin reçinelerinden topladıkları, bitkilerden aldıkları hammaddelerle kendi ürettikleri bal, bal mumu ve kendi enzimleriyle oluşturdukları doğal bir hammaddedir. Arılar propolisi kendi kovanlarını korumak, kovandaki delikleri kapatmak ve kovana dışarıdan girebilecek yabancı maddeleri tutması amacıyla üretirler. Arılar için büyük öneme sahip olan propolis, alternatif tıpta tedavi yöntemlerinde yaygın olarak kullanılırken aynı zamanda halk arasında da sıklıkla tercih ediliyor” dedi.
Propolisin maymun çiçeğine ne kadar etkili olduğunu görmek amacıyla çalışma başlattıklarını belirten Sivas Cumhuriyet Üniversitesi İleri Teknoloji Araştırma ve Uygulama Merkezi (CÜTAM) Müdürü Doç. Dr. Ebru Yabaş, “Tarımsal faaliyetlerle öne çıkan Sivas, arıcılığın başkenti olarak biliniyor. Yaz aylarının sonuna gelmiş olduğumuz şu günlerde arı ürünlerinin sağımının da sonuna gelindi. Araştırma ekibimizle arı ürünlerinden propolis üzerine çalışmalar yapmaktayız. Yaptığımız araştırmalar ve çalışmalar neticesinde halk arasında propolisin pek çok hastalıkta tüketildiğini gördük’’ dedi.

Propolisin alternatif tıpta da yoğun tüketildiğini söyleyen Doç. Dr. Ebru Yabaş, “Propolisin ham halinin suda çözünürlüğü oldukça az. Bundan dolayı da vücut içerisinde beklenen etkinliğini tam olarak karşılayamıyor. Laboratuvarımızda ön çalışmalar yaparak propolisi suda tamamen çözünür hale getirdik ve hastalıklar üzerindeki etkisini artırmayı hedefledik. Suda çözünür hale getirdiğimiz propolis üzerine antimikrobiyal çalışmalarımızı gerçekleştirdik. Sonuçta doğal halinden çok daha etkili antimikrobiyal aktivite gösterdiğini gördük. Literatüre baktığımızda son çalışmalarda propolisin antiviral etkiye sahip olduğu yani virüsler üzerinde de etkin olduğunu gözlemledik. Bu bağlamda maymun çiçeğine karşı ne kadar etkili olduğunu görmek amacıyla çalışmalarımızı başlattık” şeklinde konuştu.